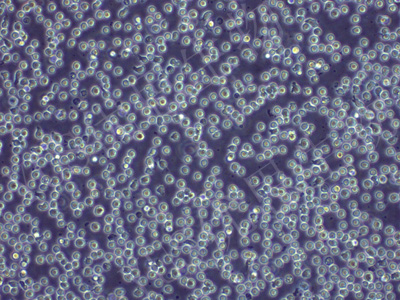

产品中心
产品中心
-

HT-29-GFP 人结直肠腺癌细胞(绿色荧光标记)(STR鉴定)
货号:YLH665规格: 1*10^6 -

A549-GFP 人非小细胞肺癌细胞(绿色荧光标记)(STR鉴定)
货号:YLH666规格: 1*10^6 -

PC-3-GFP 人前列腺癌细胞(绿色荧光标记)(STR鉴定)
货号:YLH667规格: 1*10^6 -

Hep G2-GFP 人肝母细胞瘤细胞(绿色荧光标记)(STR鉴定)
货号:YLH669规格: 1*10^6 -

MCF-7-GFP 人乳腺癌细胞(绿色荧光标记)(STR鉴定)
货号:YLH670规格: 1*10^6 -
K-562-GFP 人慢性髓原白血病细胞(绿色荧光标记)(STR鉴定正确)
货号:YLH671规格: 1*10^6 -

HCT 116-GFP 人结肠癌细胞(绿色荧光标记)(STR鉴定)
货号:YLH672规格: 1*10^6 -

AGS-GFP 人胃腺癌细胞(绿色荧光标记)(STR鉴定)
货号:YLH673规格: 1*10^6 -

PANC02-luc 小鼠胰腺癌细胞(荧光素酶标记)(STR鉴定)
货号:YLM005规格: 1*10^6 -

ID8-luc 小鼠卵巢上皮癌细胞(荧光素酶标记)(种属鉴定)
货号:YLM061规格: 1*10^6 -

B16-F10/OVA 小鼠黑色素瘤细胞转染OVA(种属鉴定)
货号:YLM103规格: 1*10^6 -

H22-luc 小鼠肝癌细胞(荧光素酶标记)(STR鉴定)
货号:YLM104规格: 1*10^6
在线咨询
Online consultation

关注微信公众号


